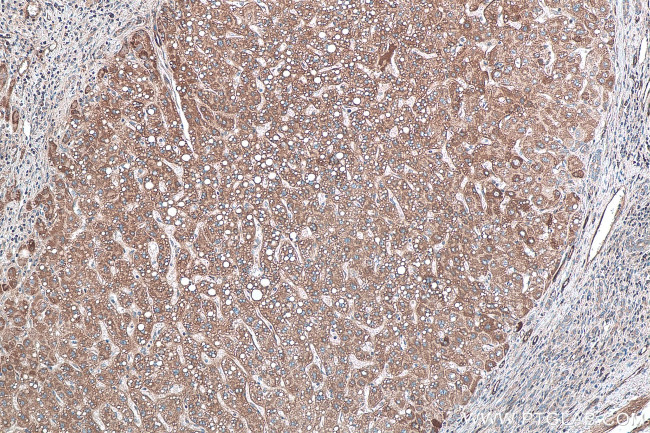
TNC/Tenascin-C Antibody in Immunohistochemistry (Paraffin) (IHC (P))

Search
Proteintech
TNC/Tenascin-C Polyclonal Antibody
{{$productOrderCtrl.translations['antibody.pdp.commerceCard.promotion.promotions']}}
{{$productOrderCtrl.translations['antibody.pdp.commerceCard.promotion.viewpromo']}}
{{$productOrderCtrl.translations['antibody.pdp.commerceCard.promotion.promocode']}}: {{promo.promoCode}} {{promo.promoTitle}} {{promo.promoDescription}}. {{$productOrderCtrl.translations['antibody.pdp.commerceCard.promotion.learnmore']}}
产品信息
27789-1-AP
种属反应
宿主/亚型
分类
类型
抗原
偶联物
形式
浓度
规格
纯化类型
保存液
内含物
保存条件
运输条件
产品详细信息
Aliquoting is unnecessary for -20°C storage.
靶标信息
Tenascin is a high molecular weight, multifunctional, extracellular matrix glycoprotein expressed in association with mesenchymal-epithelial interactions during development and in the neovasculature and stroma of undifferentiated tumors (Erickson and Bourdon 1989). It has been described under a variety of names: cytotactin, hexabrachion protein, J1, myotendinous antigen (MI) and glioma mesenchymal extracellular matrix (GMEM). The tenascin molecule is a disulfide-linked hexamer. The expression of tenascin is associated with development and growth, both normal and pathological, whereas the distribution in normal adult tissue is restricted.
仅用于科研。不用于诊断过程。未经明确授权不得转售。
篇参考文献 (0)
生物信息学
蛋白别名: Cytotactin; deafness, autosomal dominant 56; ECM glycoprotein; TNC-14/AD1/16; Glioma-associated-extracellular matrix antigen; GMEM; GP 150-225; Hexabrachion; hexabrachion (tenascin); JI; MGC144208; MGC144209; MGC167029; Myotendinous antigen; Neuronectin; Tenascin; Tenascin-C; tenascin-C additional domain 1; tenascin-C FN type III repeat domain; tenascin-C AD1; TN; TN-C; unnamed protein product
基因别名: 150-225; DFNA56; GMEM; GP; HXB; JI; TN; TN-C; TNC
UniProt ID: (Human) P24821
Entrez Gene ID: (Human) 3371